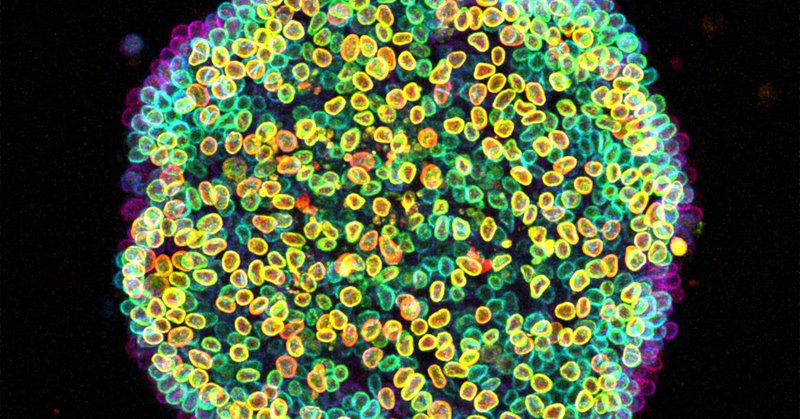
Tweet card summary image

Özge Özgüç
@oozguc
Followers
1K
Following
9K
Media
47
Statuses
6K
Cellular & Developmental Mechanics || Postdoctoral researcher @XavierTrepat 's lab @IBECBarcelona || Ph.D with @maitrejl @institut_curie || same name on 🟦
Joined December 2011
And I can't imagine a better timing to see my PhD story out @PLOSBiology ! https://t.co/8EiVNuxP1N Check it out to see how actomyosin cortex maturates through cleavage stages before it gets busy with driving the morphogenesis and how we can see these changes using #PeCoWaCo !
2
2
23
Thank you to organisers Alex Dunn, Zev Gartner @ZevGartner, Adrian Jacobo @Adrian_Jacobo and Matthew Kutys and everyone who joined us for our Workshop on New Technologies for Studying and Reprogramming Development. #BiologistsWorkshops
https://t.co/DfAVCT5EQi
0
2
8
A gourd-geous image of our lamin B1 cell line for your Halloween cell-ebrations! 🎃🧬 📸 Thanks to @oozguc for sharing this unbe-leaf-able shot!
0
6
18
Check out the preprint of my main work in the lab of @XavierTrepat @IBECBarcelona. Many thanks to all the people involved!
New preprint! 🚨 We uncover a slow adaptation to stretch that links star-bundling of keratin filaments with nuclear escape from its keratin cage. Led by @tom_golde 🙌 @IBECBarcelona
https://t.co/HZVLYVkcde
0
5
10
Have you ever thought about inflating tissues? Or maybe quickly deflating those inflated tissues? New #EpithelialMechanics pre-print: https://t.co/b7PVuHZVCO 🧵with pressure control, multiscale buckling, patterned wrinkling
3
25
91
to buckle or not to buckle that is the question🤔 So great to see this work out!! Big congrats to @onenimesa and the team!!👏
🚨 Second preprint of the week! We uncover the multiscale dynamics of active viscoelastic buckling in epithelia. We harness these mechanical instabilities for synthetic morphogenesis. Led by @onenimesa🙌. Theory by Marino Arroyo and team. https://t.co/Gtmqggt4ou
0
1
11
tissue origami 😍
How to turn a layer of fibroblasts into a tulip 🌷? Check out our new pre-print on shape-programmable living surfaces. Led by @pauguillamat @IBECBarcelona
https://t.co/iwNhsfXC3H
0
0
13
Featured image with Özge Özgüç: the Node–FocalPlane image competition Find out more about @oozguc and the story behind "Cell-estial bloom", which won the image competition we organised with @focalplane_jcs: https://t.co/yKRJXIrwk1
0
2
18
The Node-FocalPlane image competition at #biologists100. All the votes are now in, and we can announce our three prize winners: @oozguc, @Allan_littlecar and @jupeloggia. Read more ⤵️:
focalplane.biologists.com
Announcing the winners of the Node–FocalPlane image competition. - News
0
5
12
🤯
🎉Congratulations to the Top 3 images from the Node–FocalPlane image competition! 1️⃣"Cell-estial bloom" by @oozguc 2️⃣"Dancing actinotroch" by @Allan_littlecar 3️⃣"Who’s active?" by @jupeloggia
https://t.co/1fWp0JaKeF
@focalplane_jcs #biologists100
0
4
33
On my way to to the International Dutch Embryo Model Meeting 2025! 🚆 Excited to dive into the latest advances and have some great discussions. If you’re around and curious about mechanics in development / mechanically accessible models, come find my poster!! #IDEMM25
0
0
10
My image on display at #Biologists100! 🖼️🔬 So surreal to see “Cell-estial Bloom” showcased in this gallery among so many stunning images! Huge thanks to @LFort8 for sending me this photo. Also: ✨ it is the last day to vote! ✨ https://t.co/FS7wMqYKOR
1
3
99
Amidst these troubling times, I have some positive personal news to share: I will be joining @IMBA_Vienna as a new group leader this fall! 🎉 I am excited for fun projects, surprising discoveries, and great discussions within the fantastic science community @viennabiocenter.
We are excited that former Birnstiel Award laureate @KStapornwongkul will soon join the campus upon starting her lab at @IMBA_Vienna! https://t.co/qQVDOG5y68
8
16
148
Exiting news! We have revived our tradition of the YEN Image Competition. Please submit your science images and art by the 1st May 2025 and follow us to get updates on where to vote!
1
10
22
My image is shortlisted and will be displayed at #100Biologists! 🎉 This “Cell-estial Bloom” features LaminB-labeled cells from @AllenInstitute glowing in all their fluorescent glory!✨ All very incredible images—check them out and vote for your favorite (Hope it’s mine! 🤞)!
Voting is open in our image competition with @the_Node. Thanks to everyone that entered, and congratulations to our final 15. Now, it's your turn to pick your favourite! Look out for our gallery at the Biologists @ 100 conference #biologists100. https://t.co/DqXxGjnkGR
1
11
101
Bir kanun değişimine bakar, iki birbirini seven yetişkinin evlenip aile olması #AileYılı
643
834
12K
It is #FluorescenceFriday! Perfectly suited for Valentine’s Day—a 2-cell stage mouse embryo where actin staining created a heart-shaped negative space around its nucleus🔬. Captured it 4 years ago, but still one of my favorites for this time of year ❣️
0
8
56
We have a new #stopdoing #science meme, courtesy of Miquel @mboschp from the @XavierTrepat lab. Late for #mechanobiology Monday, but here to stay on your lab meme boards forever.
0
1
5
No need for explosives, this year's firework show is cell-powered! 🔬💥 Check out the "fireworks" created by cells pulling on the substrate and displacing tiny beads, visualized with #3DTFM ! 🎇 Let’s make 2025 explosive with science! 👩🔬🎉 #HappyNewYear
0
2
23
🎉Excited to announce job openings in our new lab at @MPI_Bio /FML in Tübingen!🇩🇪Looking for enthusiastic colleagues to explore regeneration together! We have positions for: 🔬Research Technician 💻Bioinformatician 🎓PhD studentship 🧪🔬📖 Postdoc Details and links below👇
4
90
247